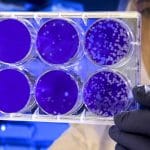
Nuovi incredibili virus arrivano da Artico

Lo sapevi che le nostre case sono popolate da migliaia di microbi, fortunatamente la scienza ci spiega che nella maggior parte dei casi non ci sono pericoli.

Soprattutto per gli amanti dell’igiene e della pulizia, a sentire certi dati si rischia un colpo: nascosti nelle nostre case vivono in media 9.000 diverse specie di microbi.
Prima di correre a disinfestare la propria abitazione, bisogna però sapere che la maggior parte di questi “ospiti” sono innocui come ha mostrato uno studio dell’Università del Colorado che ha analizzato geneticamente la polvere prelevata in 1.200 appartamenti, rivelando la presenza di queste creature microscopiche.
“La maggior parte dei funghi sembra provenire dall’esterno. Entrano attraverso il nostro abbigliamento, o finestre e porte aperte. Perciò il miglior predittore di quali tipi di funghi sono presenti in casa è il luogo in cui questa si trova“, ha commentato Noah Fierer, professore associato di ecologia e biologia evolutiva, che ha condotto lo studio.
Ma lo stesso ricercatore tranquillizza: “Non dobbiamo preoccuparci dei germi che popolano le nostre case, sono un dato di fatto. Stanno intorno a noi, sulla nostra pelle e nell’ambiente che ci circonda, e per la maggior parte sono innocui“.
E poco importa che lo studio abbia riguardato gli Stati Uniti: “In qualunque altra parte del mondo non cambierebbe gran che“, assicura Fierer.
Scarica la nostra app e ricevi notizie, curiosità, misteri, scoperte e tecnologia direttamente sul tuo smartphone.
Scarica per AndroidMi occupo di fornire agli utenti delle news sempre aggiornate, dal gossip al mondo tech, passando per la cronaca e le notizie di salute. I contenuti sono, in alcuni casi, scritti da più autori contemporaneamente vengono pubblicati su Veb.it a firma della redazione.